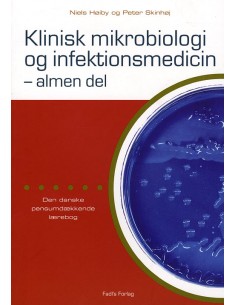
Klinisk mikrobiologi og...

Your cart
Der er ikke flere varer i din indkøbskurv
Krop og sind
Medicin, sundhed og sygdom
Klinisk mikrobiologi og infektionsmedicin - almen del
Børn og forældre
Literacy og læringsmål
Krop og sind diverse
Yoga helt enkelt
Børn og forældre